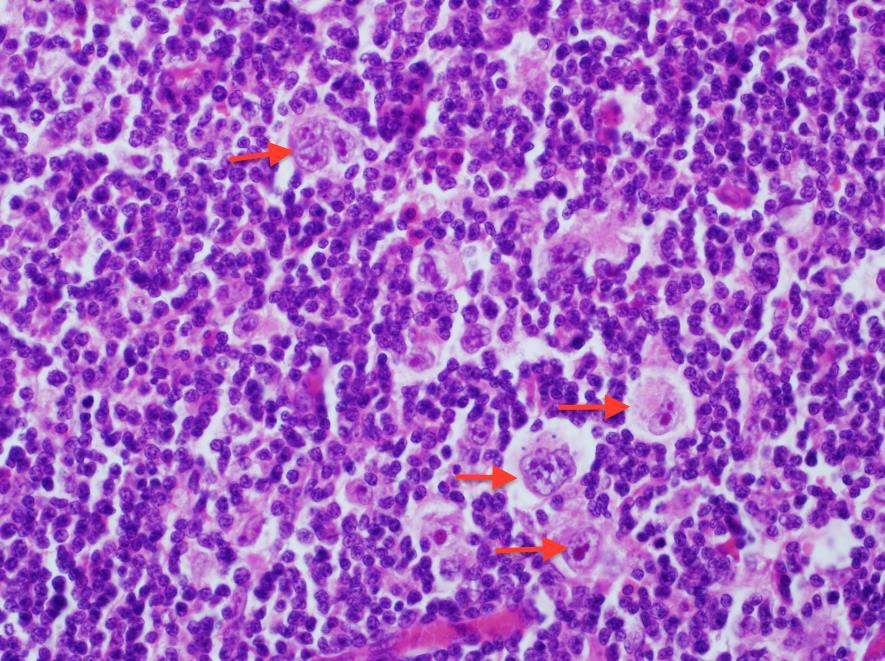
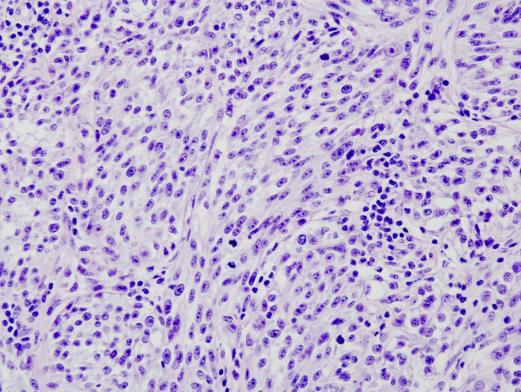

Wyszukaj egzamin lub pytanie
Egzamin PES Patomorfologia / wiosna 2019
120 pytań
Pytanie 1
Co jest charakterystyczne dla colitis ulcerosa w obrazie mikroskopowym?
Pytanie 2
U 25-letniego mężczyzny skarżącego się na uczucie zmęczenia, duszność oraz utratę wagi ciała, u którego na zdjęciu Rtg klatki piersiowej stwierdzono guz śródpiersia, wykonano mediastinoskopię. W preparatach mikroskopowych stwierdzono obraz jak poniżej. Co należy podejrzewać?
Pytanie 3
Które z wymienionych komórek ulegają hipertrofii, ale nie hiperplazji?
Pytanie 4
W jakich strukturach anatomicznych duża liczba komórek apoptotycznych jest bardzo częsta i nie ma znaczenia patologicznego?
Pytanie 5
Obrzęk hiperwolemiczny zależny jest od retencji sodu i wody, która zależna jest od współdziałania:
Pytanie 6
Mikrofotografia przedstawia naciek złożony z nierozpadających się granulo- cytów obojętnochłonnych i komórek 'żółtakowych' wokół kolonii bakterii. W barwieniu metodą Grama zewnętrzna cześć kolonii jest Gram+ centrum Gram-, a na obwodzie zmian obecny jest objaw 'wschodzącego słońca'. Obraz taki charakterystyczny jest dla:

Pytanie 7
Złośliwy nowotwór osłonek nerwowych (malignant peripheral nerve sheath tumor, MPNST) i mięsak maziówkowy (synovial sarcoma) wykazują w obrazie mikroskopowym wiele cech wspólnych, w tym:
Pytanie 8
W rozmazie z biopsji aspiracyjnej cienkoigłowej guzka tarczycy uzyskano bogatokomórkowe rozmazy, w których widoczne są liczne grupy tyreocytów tworzących struktury mikrofollikularne. Obraz cytologiczny odpowiada:

Pytanie 9
Nowotwór, którego typowe utkanie przedstawiono na zdjęciu poniżej ma charakter:

Pytanie 10
Włókniejący guz drobnookrągłokomórkowy (ang. desmoplastic small round cell tumor, DSRCT) to:
Pytanie 11
Utkanie mikroskopowe mięsaka nabłonkowatego (epithelioid sarcoma) charakteryzuje się:
Pytanie 12
Wskaż prawdziwe stwierdzenie dotyczące mięśniakomięsaka gładkokomórkowego (leiomyosarcoma) tkanek miękkich:
Pytanie 13
Wg najnowszej klasyfikacji nowotworów tkanek miękkich (WHO 2013) różnicowanie pomiędzy atypowym guzem tłuszczakowatym (atypical lipomatous tumor, ATL) i dobrze-zróżnicowanym tłuszczakomięsakiem (well differentiated liposarcoma) opiera się na ocenie:
Pytanie 14
Do ostatecznego rozpoznania nowotworu, którego utkanie zaprezentowano na rycinach poniżej wystarczy:
Pytanie 15
Opisana przez prof. Józefa Laskowskiego jednostka morfologiczno- kliniczna o nazwie sarcoma aponeuroticum wg aktualnych poglądów wchodzi w skład większej grupy nowotworów określanych terminem:
Pytanie 16
Wyznacznikami złego rokowania u chorych na mięsaka maziówkowego (synovial sarcoma) są:
Pytanie 17
Wskaż prawdziwe stwierdzenie dotyczące nowotworu o typie angiomatoid fibrous histiocytoma:
Pytanie 18
Możliwość zastosowania tzw. terapii celowanej (spersonalizowanej) w nowotworach tkanek miękkich dotyczy chorych:
Pytanie 19
Do genów supresorowych nowotworów należą wszystkie poniższe, z wyjątkiem:
Pytanie 20
O niestabilności mikrosatelitarnej w raku jelita grubego może świadczyć:
Pytanie 21
Komórki Warthina-Finkeldeya są typowe dla:
Pytanie 22
W krioglobulinemii dochodzi do:
Pytanie 23
Do nowotworów, które mają związek z infekcją EBV, nie należy:
Pytanie 24
Wskaż prawdziwe stwierdzenie dotyczące zapalenia autoimmunizacyjnego wątroby (AIH):
Pytanie 25
W diagnostyce różnicowej naczyniaków krwionośnych i limfatycznych znaczenia nie ma ekspresja:
Pytanie 26
Do czynników dobrego rokowania w neuroblastoma nie należy:
Pytanie 27
U 40-letniej kobiety w preparacie histopatologicznym z powiększonego węzła chłonnego na szyi o średnicy ok. 5 cm stwierdzono: liczne grudki chłonne z zanikającymi ('wypalonymi') ośrodkami rozmnażania i szeroko uwarstwioną strefą płaszcza, przypominającą przekrój przez cebulę oraz bardzo bogatą sieć zawłoś- niczek o pogrubiałych ścianach, ulegających szkliwieniu między grudkami. Powyższy obraz przemawia za rozpoznaniem:
Pytanie 28
U mężczyzny lat 50 ze splenomeglią, pancytopenią i tzw. suchą punkcją szpiku, w trepanobioptacie stwierdzono: rozlany naciek z niewielkich komórek o okrągłych lub owalnych jądrach i obfitej cytoplazmie, o obrazie przypominającym 'smażone (sadzone) jajka', z towarzyszącym przybytkiem włókien srebrochłon- nych. W badaniu immunohistochemicznym w powyższym przypadku należy spodziewać się dodatniej ekspresji:
Pytanie 29
W którym z niżej wymienionych nowotworów występuje mutacja genu C-KIT?
Pytanie 30
Wskaż typowy immunofenotyp chłoniaka Burkitta (BL): 1) CD20; 2) TdT; 3) BCL-2; 4) BCL-6; 5) CD10. Prawidłowa odpowiedź to:
Pytanie 31
Czym różni się guzkowy chłoniak Hodgkina z przewagą limfocytów (NLPHL) od podtypu bogatolimfocytarnego klasycznego chłoniaka Hodgkina (LRCHL)? 1) wiekiem występowania nowotworu; 2) częstością występowania nowotworu; 3) immunofenotypem komórek nowotworowych; 4) ilością limfocytów w utkaniu nowotworu; 5) cechami morfologicznymi komórek nowotworowych. Prawidłowa odpowiedź to:
Pytanie 32
Wskaż prawdziwe stwierdzenia dotyczące nowotworów śródpiersia: 1) grasiczaki stanowią grupę nowotworów mieszanych, zbudowanych zazwyczaj z dwóch komponentów nowotworowych: nabłonkowego i limfocytarnego; 2) komponent limfocytarny stanowią głównie niedojrzałe limfocyty T o immunofenotypie: CD3+, CD1a+, TdT+; 3) grasiczaki występują wyłącznie w śródpiersiu przednim i górnym; 4) najczęstszą postacią nowotworów germinalnych w śródpiersiu jest dojrzały potworniak; 5) w rakach grasicy, podobnie jak w rakach płuc, stwierdza się ekspresję TTF-1. Prawidłowa odpowiedź to:
Pytanie 33
Wskaż fałszywe stwierdzenie dotyczące nowotworów pierwotnych płuc:
Pytanie 34
Który z niżej wymienionych markerów nie jest typowy dla raka drobnokomórkowego płuca (SCLC)?
Pytanie 35
W badaniu histopatologicznym guza płuca stwierdzono utkanie gruczola- koraka przypominającego raka jelita grubego. Wskaż cechy wspólne, które występują w gruczolakoraku jelitowym będącym postacią histologiczną gruczolakoraka płuca i przerzucie gruczolakoraka jelita grubego do płuca: 1) CK 20+; 2) CDX2+; 3) CD5/6+; 4) heterogenna budowa histologiczna guza z ekspresją TTF1+ i CK7+; 5) cechy histologiczne i immunofenotypowe w całym utkaniu typowe dla gruczolakoraka jelita grubego. Prawidłowa odpowiedź to:
Pytanie 36
Przyczyną obrzęku płuc nie jest:
Pytanie 37
Wskaż markery immunohistochemiczne, wykorzystywane do oceny kierunku różnicowania mięsaków, które występują zarówno w komórkach mięśni gładkich, jak i poprzecznie prążkowanych: 1) desmina; 2) miogenina; 3) kalponina; 4) MSA; 5) SMA. Prawidłowa odpowiedź to:
Pytanie 38
Wskaż fałszywe stwierdzenie dotyczące myositis ossificans:
Pytanie 39
Cechą typową zapalnego guza miofibroblastycznego (IMT) nie jest:
Pytanie 40
Do łagodnych nowotworów tkanek miękkich nie należy:
Pytanie 41
W badaniu histopatologicznym trzustki pacjenta z objawami także ze strony innych narządów stwierdzono: zanik gruczołów, rozległe włóknienie z widocznymi wyspami Langerhansa, poszerzone przewody z zalegającą wydzieliną, metaplazję płaskonabłonkową nabłonka wyścielającego przewody. Obraz ten jest charakterystyczny dla:
Pytanie 42
Szczególną cechą gruźlicy w nabytym zespole niedoboru odporności (AIDS) nie jest:
Pytanie 43
W uogólnionym niedokrwieniu mózgu:
Pytanie 44
Wskaż fałszywe stwierdzenie dotyczące choroby Kawasaki:
Pytanie 45
Typowe zmiany występujące w przebiegu apoptozy to: 1) obkurczenie komórek i kondensacja chromatyny; 2) obrzęk komórek; 3) śmierć pojedynczych komórek; 4) reakcja zapalna w otaczających tkankach; 5) rozpad DNA z wytworzeniem fragmentów o określonej długości. Prawidłowa odpowiedź to:
Pytanie 46
Wskaż fałszywe stwierdzenie dotyczące oponiaków:
Pytanie 47
Przyczyną choroby Cushinga jest:
Pytanie 48
Który zestaw przeciwciał może potwierdzić, że guz pierwotny znajduje się w płucu w przypadku oceny histopatologicznej przerzutu do mózgu zdiagnozowanego jako adenocarcinoma?
Pytanie 49
Wskaż fałszywe stwierdzenie dotyczące siatkówczaka:
Pytanie 50
Wskaż prawdziwe stwierdzenie dotyczące chłoniaka Hodgkina:
Pytanie 51
Wskaż prawdziwe stwierdzenie dotyczące chorób pęcherzowych skóry:
Pytanie 52
Wskaż prawdziwe stwierdzenie dotyczące zespołu niewydolności oddechowej noworodków (zespołu błon szklistych):
Pytanie 53
Najczęstszym nowotworem złośliwym u dzieci do 10. r.ż. jest:
Pytanie 54
Wskaż prawdziwe stwierdzenia dotyczące endometriozy: 1) zmiany w jajnikach mogą mieć postać torbieli skórzastej; 2) ogniska endometriozy wewnętrznej zawierają elementy aktywnej błony śluzowej; 3) lokalizacja pozamaciczna obejmuje wyłącznie miednicę - jajniki i zatoka Douglasa; 4) w endometriozie stwierdza się zwiększone poziomy mediatorów zapalnych i estrogenów; 5) może prowadzić do zrostów międzypętlowych jelit. Prawidłowa odpowiedź to:
Pytanie 55
Najważniejsze cechy mikroskopowe odróżniające gruczolaka od raka pęcherzykowego minimalnie inwazyjnego tarczycy obejmują:
Pytanie 56
Wskaż fałszywe stwierdzenia dotyczące guzów torbielowatych trzustki: 1) nowotwory śluzowe torbielowate mają łagodny przebieg; 2) występują częściej u kobiet; 3) stanowią ok. 30% wszystkich nowotworów trzustki; 4) badanie cytologiczne ich treści jest istotne w postępowaniu terapeutycznym. Prawidłowa odpowiedź to:
Pytanie 57
Wskaż prawdziwe stwierdzenie dotyczące zespołu Downa (ZD):
Pytanie 58
Wskaż fałszywe stwierdzenie dotyczące wrodzonych wad serca:
Pytanie 59
Do możliwych przyczyn zwiększenia liczby monocytów nie należy:
Pytanie 60
50-letni pacjent zgłosił się do dermatologa z powodu zmian grudkowych. Makroskopowo były to wieloboczne, płasko-wyniosłe zmiany pokryte białymi nitkami opisanymi jako prążki Wickhama. W obrazie mikroskopowym pobranym od tego pacjenta widać nacieki limfocytarne wzdłuż połączenia szkórno- naskórkowego, z cechami nadmiernego rogowacenia. Duże skupienia ziarnistości i wyraźnie zaznaczone sople naskórkowe. Na podstawie powyższego opisu można rozpoznać:
Pytanie 61
Które z poniższych stanowi czynnik ryzyka kamicy cholesterolowej pęcherzyka żółciowego?
Pytanie 62
Mikroskopowo w płucach stwierdzono przekrwienie włośniczek, a w badaniu makroskopowym obecne są: martwica komórek nabłonkowych pęcherzy- ków, błony szkliste wyściełające rozdęte przewody pęcherzykowe, obrzęk oraz śródmiąższowe i wewnątrzpęcherzykowe krwawienie, ze zgrupowaniem neutrofilów we włośniczkach. Opisane zmiany może stwierdzić w poniższych przypadkach, z wyjątkiem:
Pytanie 63
40-letni pacjent zgłosił się do lekarza z powodu krwiomoczu. Po wykona- niu badań obrazowych stwierdzono u pacjenta guz kory lewej nerki, o średnicy 4 cm. Składał się on ze zwakuolizowanych komórek, z niewielkimi, okrągłymi jądrami oraz innych przypominających swoim wyglądem komórki nabłonka kanalikowego z małymi okrągłymi jądrami i różową ziarnistą cytoplazmą. Mutacji którego genu należy spodziewać się w przypadku opisanej powyżej zamiany?
Pytanie 64
W przebiegu procesu nowotworowego zajmującego węzły chłonne i szpik kostny zaobserwowano u pacjenta makroglobulinemię Waldenströma spowodowaną wysokim poziomem IgM we krwi. W badaniu moczu nie stwierdza się białka Bence'a-Jonesa ani łańcuchów lekkich. Które z poniższych rozpoznań najbardziej odpowiada opisowi?
Pytanie 65
35-letnia pacjentka zgłosiła się do lekarza rodzinnego z powodu gorączki i złego samopoczucia. W ciągu ostatniego tygodnia zanotowała również znaczną utratę masy ciała. W ciągu kolejnych dni pojawiły się kolejne objawy w postaci nadciśnienia, bólów brzucha oraz krwawych stolców oraz dodatkowo dokuczające rozlane bóle mięśni. W badaniu histopatologicznym wycinka z nerki uwidoczniony był naciek zapalny obejmujący cała grubość ścian tętnic, złożony z granulocytów obojętnochłonnych oraz komórek jednojądrzastych. Oprócz tego stwierdzono również zakrzepicę światła naczyń i martwicę włóknikowatą. W oparciu o obraz kliniczny i histopatologiczny wskaż najbardziej prawidłowe rozpoznanie:
Pytanie 66
W przebiegu których z poniższych chorób występują zmiany polipowate typu hamartoma? 1) zespół Peutza-Jeghersa; 2) choroba Cowdena; 3) zespół Gardnera; 4) zespół Turcota; 5) zespół Downa. Prawidłowa odpowiedź to:
Pytanie 67
W badaniu histopatologicznym wycinka z płuc obserwuje się pogrubienie zrębu płucnego, obrzęk oraz nacieczenie przez limfocyty i makrofagi. Dodatkowo widoczne są olbrzymie jednojądrzaste komórki nabłonkowe z wewnątrzjądrowymi inkluzjami wirusowymi. Który z poniższych patogenów może stanowić przyczynę wyżej opisanego stanu?
Pytanie 68
Klasyfikacja Shimady dotycząca nerwiaka zarodkowego (neuroblastoma) uwzględnia następujące cechy, z wyjątkiem:
Pytanie 69
Do zapaleń naczyń z udziałem kompleksów immunologicznych należy:
Pytanie 70
Która z poniższych cech dotyczących podtypu luminalnego A raka piersi jest fałszywa?
Pytanie 71
23-letni mężczyzna zgłosił się do wenerologa z powodu wycieku śluzowo- surowiczej treści z cewki moczowej. W obrazie mikroskopowym materiału pobra- nego od pacjenta widoczny był obfity naciek limfocytarny. Po jednorazowym podaniu azytromycyny objawy ustąpiły. Po 4 tygodniach pacjent zaczął odczuwać bóle stawów kolanowych oraz stawów stóp. Pobrano od pacjenta preparat do badania histopatologicznego, w którym obserwuje się obrzęk kosmków błony maziowej oraz rozrost komórek wyściółki. W podścielisku błony stawowej stwierdza się zwiększoną liczbę naczyń krwionośnych, nacieczonych przez limfocyty. Natomiast powierzchnię błony stawowej pokrywa nalot włóknikowy, którego skupienia tworzą ciałka ryżowe w płynie stawowym. Którą z postaci odczynowego zapalenia stanów z największym prawdopodobieństwem można podejrzewać u tego pacjenta?
Pytanie 72
Pobrano materiał od 63-letniego pacjenta z jednej z symetrycznych zmian zlokalizowanych w okolicy przynosowego rąbka rogówki. Klinicznie zmiany są miękkie o żółtawym zabarwieniu, nieunaczynione. W preparacie histopatolo- gicznym widoczne jest zwyrodnienie zasadochłonne, akantoza, dyskeratoza i hiperkeratoza. Której z poniższych patologii towarzyszy wyżej opisany obraz?
Pytanie 73
Do kliniki dermatologicznej zgłosił się 35-letni mężczyzna, z powodu dobrze napiętych pęcherzy podnaskórkowych, pojawiających się symetrycznie w okolicach łokci i kolan. W preparacie histopatologicznym obserwuje się mikroropnie w szczytach brodawek skórnych, w których skład wchodzą neutrofile i włóknik. Ponadto w skórze właściwej stwierdza się nacieki zapalne okołonaczyniowe z komórek jednojądrowych, neutrofilów i eozynofilów. Dodatkowo po wykonaniu badań metodą immunofluorescencji bezpośredniej wykryto ziarniste złogi IgA w szczytach brodawek skórnych. Najbardziej prawdopodobnym rozpoznaniem u tego pacjenta będzie:
Pytanie 74
Najczęstszą przyczyną nieurazowego krwotoku podpajęczynówkowego jest:
Pytanie 75
Nowotwór jajnika zbudowany z obfitego zrębu zawierającego gniazda nabłonka typu przejściowego to:
Pytanie 76
Najczęstszymi polipami żołądka są:
Pytanie 77
Rak płaskonabłonkowy przełyku zazwyczaj związany jest z: 1) przewlekłą chorobą refluksową; 2) zakażeniem EBV; 3) zespołem Plummera-Vinsona; 4) nadużywaniem alkoholu; 5) paleniem tytoniu. Prawidłowa odpowiedź to:
Pytanie 78
Zespół, w którym ogólnoustrojowe pobudzenie krzepnięcia prowadzi do zwiększenia zużycia czynników koagulacji i płytek to:
Pytanie 79
Bardzo agresywny chłoniak z obwodowych limfocytów B, rozwijający się przeważnie poza węzłami i bardzo często związany z infekcją EBV to:
Pytanie 80
Martwica włóknikowata naczyń tętniczych jest typowa dla: 1) nadciśnienia łagodnego; 2) nadciśnienia złośliwego; 3) guzkowego zapalenia tętnic; 4) miażdżycy; 5) tocznia rumieniowatego układowego. Prawidłowa odpowiedź to:
Pytanie 81
Guzkowe stwardnienie kłębuszków nerkowych jest zmianą typową dla:
Pytanie 82
Wskaż prawdziwe stwierdzenia dotyczące nowotworu podścieliskowego przewodu pokarmowego (GIST): 1) jest najczęstszym mezenchymalnym nowotworem jamy brzusznej; 2) często lokalizuje się w żołądku; 3) wywodzi się z komórek śródmiąższowych Cajala; 4) w jelicie cienkim przebiega łagodniej niż GIST zlokalizowany w żołądku; 5) częstość występowania GIST ma związek z przyjmowaniem leków (NLPZ). Prawidłowa odpowiedź to:
Pytanie 83
Główne kliniczne objawy niedoczynności przytarczyc są następstwem:
Pytanie 84
Wskaż prawdziwe stwierdzenie dotyczące siedzących gruczolaków ząbkowanych jelita grubego:
Pytanie 85
Wskaż prawdziwe stwierdzenia dotyczące choroby Leśniowskiego- Crohna: 1) nie prowadzi do zwężenia światła jelita; 2) typowe są tzw. mikroskopowe zmiany 'skaczące'; 3) najczęściej zmiany zajmują końcowy odcinek jelita krętego i kątnicę; 4) zmiany zapalne ograniczone są do błony śluzowej i podśluzowej; 5) często powstają szczeliny między fałdami błony śluzowej. Prawidłowa odpowiedź to:
Pytanie 86
Zaburzenia predysponujące do rozwoju zespołu serca płucnego to: 1) nadciśnienie tętnicze; 2) przewlekła obturacyjna choroba płuc; 3) mukowiscydoza; 4) rozstrzenie oskrzeli; 5) choroba niedokrwienna serca. Prawidłowa odpowiedź to:
Pytanie 87
Zapalenie ziarniniakowe tętnic dużego i średniego kalibru, które charakte- ryzuje się głównie zaburzeniami ze strony oczu i znacznym osłabieniem tętna tętnic kończyn górnych to:
Pytanie 88
Głównym czynnikiem ryzyka rozwarstwienia tętnicy głównej jest:
Pytanie 89
Do komórek prezentujących antygen należą: 1) granulocyty kwasochłonne; 2) komórki Langerhansa w naskórku; 3) grudkowe komórki dendrytyczne węzłów chłonnych i śledziony; 4) makrofagi; 5) komórki tuczne. Prawidłowa odpowiedź to:
Pytanie 90
U chorych na cukrzycę nadmierne gromadzenie glikogenu dotyczy: 1) mięśni szkieletowych; 2) komórek nabłonka cewek nerki; 3) komórek beta wysepek trzustkowych; 4) komórek mezangialnych kłębuszków nerkowych; 5) komórek mięśnia sercowego. Prawidłowa odpowiedź to:
Pytanie 91
Rozszerzenie naczyń w tkance objętej procesem zapalnym zależne jest od działania:
Pytanie 92
Spośród niżej wymienionych wskaż cechę, która determinuje rozpoznanie SLL (chłoniaka z małych limfocytów) a nie CLL (przewlekłej białaczki limfocytowej):
Pytanie 93
Wszystkie cechę, która nie dotyczy AML (ostrej białaczki szpikowej):
Pytanie 94
Komórki nowotworowe są 3-4 razy większe od małych limfocytów, jądra mogą być okrągłe/owalne/pęcherzykowe/wielopłatowe/nieregularne z wyraźnymi jąderkami, mogą mieć 'anaplastyczny' wygląd. Przedstawiony opis najbardziej pasuje do chłoniaka:
Pytanie 95
U 45-letniego mężczyzny stwierdzono nowotwór serca rosnący jako pojedyncza masa, o średnicy 2 cm, mająca miękką 'przeświecającą' budowę, mikroskopowo 'łagodny' wygląd i powodujący zaburzenie przepływu krwi. Wskaż najlepsze skojarzenie:
Pytanie 96
W trakcie sekcji zwłok zauważono obecność w sercu małych oraz średniej wielkości wyrośli widocznych głównie na zastawkach (po obu stronach), a także na strunach ścięgnistych oraz ogniskowo na powierzchni wsierdzia obu komór. Przedstawiony opis sugeruje:
Pytanie 97
Wskaż możliwą przyczynę przerostu prawej komory:
Pytanie 98
Opis: makroskopowo listek trzewny opłucnej ma wygląd kostki brukowej, płuco na przekroju ogniskowo jest twarde, histologicznie widoczne jest włóknienie śródmiąższowe o różnym nasileniu oraz w różnych fazach, później występuje włóknienie o strukturze 'plastra miodu' - najbardziej pasuje do:
Pytanie 99
Najczęstszym powodem występowania pylicy jako choroby zawodowej płuc jest narażenie na:
Pytanie 100
Występowanie ziarniniaków zalicza się do zmian o typie:
Pytanie 101
Przebudowa miąższu wątroby związana z martwicą, zapaleniem, włóknieniem i powstawaniem zrazików pozbawionych żyły centralnej oraz narastającymi wykładnikami przewlekłej niewydolności (klinicznie i laboratoryjnie), jest najmniej prawdopodobna po zakażeniu wywołanym:
Pytanie 102
22-letni pacjent po doświadczeniach z licznymi partnerami seksualnymi (dla zwiększenia emocji uprawiał seks bez zabezpieczeń) w trakcie wakacji, poza leczeniem objawowym prącia i odbytu przeszedł także ostre zapalenie wątroby. Po kilku miesiącach pojawiły się wykładniki niewydolności wątroby. Jeżeli doszło do zakażenia wirusem HBV, w miąższu wątroby spodziewać się można najbardziej jego charakterystycznej cechy, czyli:
Pytanie 103
Wśród wymienionych wskaż najczęstszą jednostkę odpowiadającą nowotworowi łagodnemu (czasem nazywaną zmianą typu hamartoma) u pacjentów w wieku dziecięcym:
Pytanie 104
W typowym dla wieku dziecięcego nowotworze, oprócz typowego obrazu mikroskopowego tzw. małych okrągłych komórek (ang. SBCT), stwierdza się także zadziwiająco dobre rokowanie w przypadku choroby w czwartym stadium zaawansowania, opisywanym jako 'stage IVs'. Typowe zaburzenie genetyczne stwierdzane w opisanym nowotworze dotyczy genu:
Pytanie 105
U 2-letniego dziecka rozwinął się guz w jamie brzusznej. Po wycięciu i pobraniu wycinków, w obrębie nowotworu stwierdzono występowanie, przede wszystkim utkania przypominającego nowotwór zbudowany z małych okrągłych komórek (ang. SBCT). Niemniej jednak, po uważnej ocenie mikroskopowej udało się stwierdzić inne obszary m.in. zawierające głównie elementy przypominające struktury nabłonkowe albo obszary wrzecionowatych komórek tworzących podścielisko albo obszary tzw. 'blastemy'. W tym nowotworze najczęściej dochodzi do inaktywacji genu:
Pytanie 106
Choroba występuje głównie rodzinnie i jest związana z zaburzeniem budowy białka, którego duże ilości znajdują się w ścianie aorty, więzadłach (w tym także utrzymujących na właściwym miejscu soczewkę oka), jest związana z zaburzeniem w obrębie genu FBN1. Wskaż chorobę, której ten opis najbardziej odpowiada:
Pytanie 107
Komórki (czasem o znacznie powiększonych rozmiarach) zawierające wakuole, w których można zaobserwować struktury przypominające 'pomięty papier' są patognomoniczne dla:
Pytanie 108
U 26-letniego mężczyzny zdiagnozowanego w dzieciństwie jako pacjent z mutacją w obrębie genu CFTR, (zaburzenie prowadzące do upośledzenia transportu jonów chloru), stwierdzono typowe cechy choroby takie jak: przebyte smółkowe zapalenie jelita grubego oraz nawracające zapalenia układu oddecho- wego. Do spodziewanych innych następstw tej choroby nie należy:
Pytanie 109
Najbardziej typową zmianą morfologiczną stwierdzaną w płucach w przebiegu wstrząsu jest/są:
Pytanie 110
Zasadnicza cecha charakterystyczna skrobiawicy, niezależnie od przyczyny, to:
Pytanie 111
Włóknienie jako następstwo reakcji zapalnej jest wywołane przedłużającą się aktywacją:
Pytanie 112
Zębopochodny guz wapniejący:
Pytanie 113
W przebiegu skrobiawicy uogólnionej złogi amyloidu mogą odkładać się:
Pytanie 114
Najczęstszym nowotworem śródpiersia u ludzi w 3. dekadzie życia jest:
Pytanie 115
Wskaż panel immunohistochemiczny właściwy dla odróżniania nisko zróżnicowanego raka z nabłonka dróg moczowych i raka gruczołu krokowego:
Pytanie 116
U 30-letniej kobiety, której ojciec zmarł w 40. roku życia z powodu raka jelita grubego wykonano badanie endoskopowe i stwierdzono obecność licznych polipów jelita grubego. Najbardziej prawdopodobne, że mutacja odpowiedzialna za ten stan rzeczy wystąpiła w genie:
Pytanie 117
Mikrofotografia przedstawia obraz histopatologiczny guza trzonu kręgowego u 65-letniego mężczyzny. Jakie rozpoznanie należy wziąć pod uwagę w diagnostyce różnicowej i jakie barwienia wykonać?

Pytanie 118
W przewlekłym odczynowym zapaleniu węzła chłonnego dominująca reakcja ze strony strefy B występuje w:
Pytanie 119
Wskaż histologiczną cechę typową dla nerwiaka osłonkowego:
Pytanie 120



